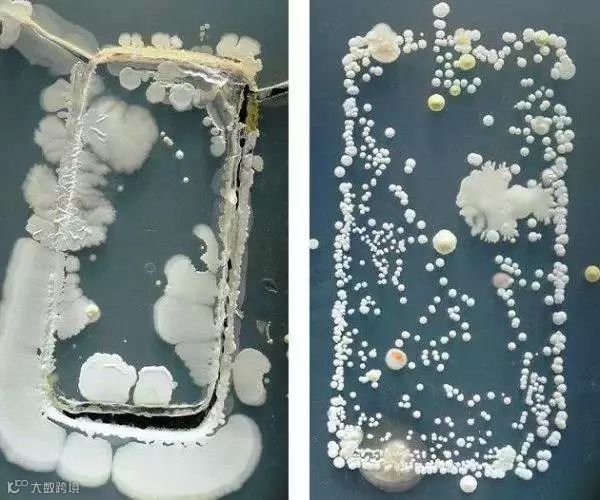
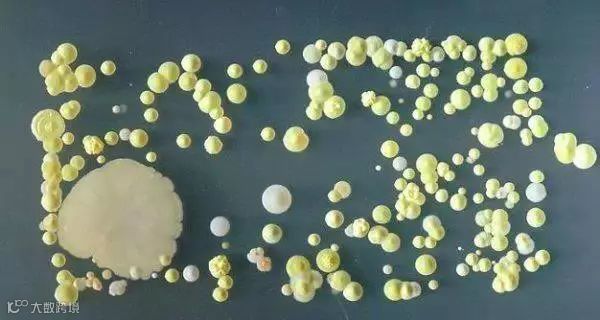
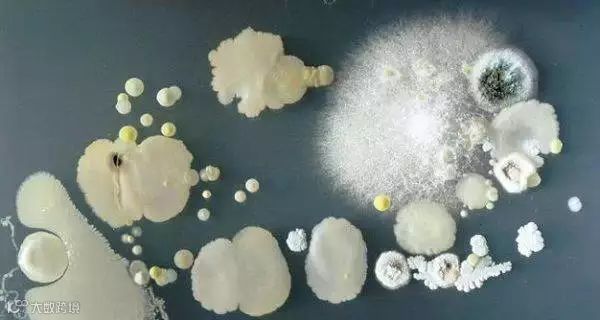
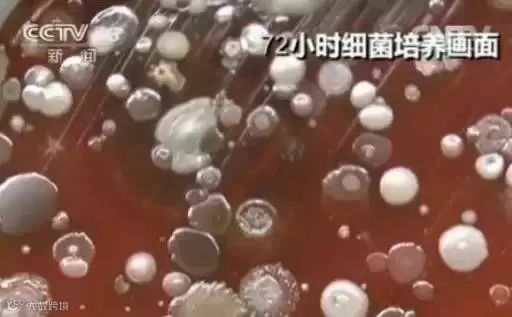
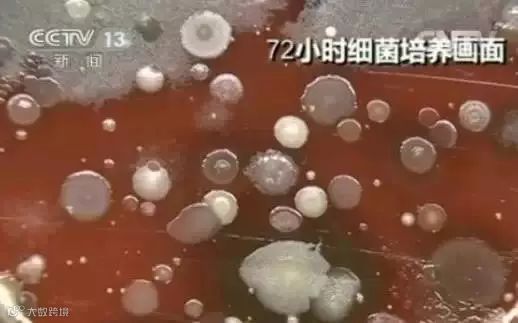

谁是你最亲密的TA
不是他?也不是她!
答案竟是它
手机

你白天捧着它
晚上捧着它
没事的时候摸摸它
有事的时候玩玩它……
然而
它却比厕所冲水按钮还脏
不骗你,
央视已经曝光了
呃,那画面“太美”
建议正吃东西的小伙伴先别看
如果你几乎每时每刻都把手机放在身边
那你的手机上很有可能堆满了细菌
下面放的照片告诉你真相——
注意!前方高能,请坐稳扶好!
↓↓

一起来看看实验检测
↓↓
检测人员将采集到的包括出租车司机的小屏幕手机、小朋友不停在玩着手机游戏的苹果手机等,不同的几部手机提取样本分别与培养皿进行涂抹接触。在此之后,所有样本放置于恒温恒湿的孵箱之内静待观察。

经过了第一个24小时,大部分的培养皿中都长出了小如针尖,大如小米大小的菌落,但一部经常被擦拭的手机培养皿中与之前并无区别,看似非常干净。但在第二个24小时过后,之前看似干净的培养皿中也未能幸免,同样长出了很多肉眼可见的菌落,而之前针尖大小的菌落变成了米粒大小。
在经过了第三个24小时,我们发现送检的每一个培养皿中都长出了不同颜色以及大小清晰的菌落,最大的有硬币大小。
△这是一位经常用酒精擦拭手机的出租汽车司机的手机细菌情况。
△这是一位在手机屏幕脏得看不下去的时候会用手擦拭的女士的手机细菌情况。

△这个是一位小朋友父亲手机的细菌情况。

△这个是一位称手机脏得像便后不洗手一样的大娘的手机细菌情况。
专家表示:“有人做过实验,测试100个护士手机,有24个存在病原菌。一个密切接触公共环境的人,手机存在病原菌污染的可能性就高。手传给手机,手机又通过打电话,与鼻子、皮肤、耳朵传给打电话的人。很多病原菌会携带7天左右,特殊的还能更长到21天左右。”
文章来源:新晚报综合自央视新闻、长春晚报


点击“阅读原文”


